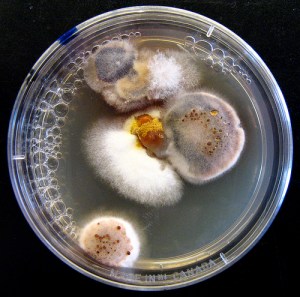
Nasty Petri Dish Wash your hands!

Time to talk about preservatives. This is a pretty touchy subject with a lot of big guns on both sides of the debate. Let’s see where we go…
The first thing to mention is that preservatives can be toxic. Of course they can. Their sole job is to kill things so that our products stay fresh and usable. Preservatives kill off nasty microbiological organisms like viruses, bacteria, yeast and mold. That’s a good thing right? Otherwise we would only have local cosmetics that have to be kept in the refrigerator and replaced every few days. No more national brands and a big upswing in the sale of portable coolers.
I mean, how clean are your hands? Pretty darn clean you think. You think incorrectly. One of my favorite show and tell demos when training new chemists is to ask them just like I asked you how clean their hands are. Then I have them put their thumb on the agar in a micro plate. (Agar is what we use as food to test for microbial growth. Give ’em food, a moist warm place to thrive and see if it can survive.)
Two days later, I show them the plates. And the amount of growth is always amazing. All kinds of bumps and fuzz of many different colors. Now we know with great certainty who washes their hands after using the restroom and who doesn’t. It is truly an eye-opener.
Wash your hands!
So if a scientist’s hands which are washed religiously and covered with gloves aren’t clean, how do you think the average person’s hands compare. Chemistry 101: A real chemist washes their hands before they use the restroom as well as after.
And you think nothing about sticking your finger into your jar of cream after a long day? Ugh!
OK, so now we know that things are dirty and that preservatives are used to combat all the nasties that can grow on our skin. So let’s cut to the chase and get to parabens.

Parabens: A group of preservatives (esters of p-hydroxybenzoic acid) used very commonly in cosmetics, food, pharmaceutical and industrial products. You can find them on labels listed as: methylparaben, propylparaben, ethylparaben, butylparaben, isopropylparaben or isobutylparaben. They were first introduced in the 1920’s, hit commercial cosmetic use in the 1930’s, were first listed as GRAS (generally recognized as safe) in 1995 by the US EPA at a combined percentage of 0.8% in cosmetic products. The average cosmetic concentration of parabens usually runs between 0.20-0.40%. And as with any material, it is possible to be allergic to parabens.
But in 2004, there was a study by Dr Philippa Darbre at the University of Reading that showed out of twenty breast tumors studied, all of them had parabens in them. Wow. That set the press in motion and before long many thought that parabens cause breast cancer. Why would they think that? Well, it seems that parabens (butylparaben is the most potent of the family) have some oestrogenic activity. Estrogen is an endocrine distrupor. Disrupt the endocrine system enough, cancer can grow. The test was published in the Journal of Applied Toxicology.
So on the one hand, there are a few studies that show a causal link between parabens and breast cancer. However, those studies bring more questions than answers. On the other hand the US, EU, Japan, the National Cancer Institute and several respected naturalists do not see any cause for alarm. The oestrogenic activity of parabens is approximately 100,000 times weaker than a woman’s natural estrogen.
Give the public what it wants. Several groups have reopened studies on parabens and more work is being. done. We should probably ban everything that causes cancer, huh?
Did you know that all plants naturally produce p-hydroxybenzoic acid? They produce parabens to protect themselves against attack by micro-organisms. Gee, just like we use them in cosmetics and personal lubricants! And guess what? Almonds, apples, broccoli, cherry, mango and many, many more have potent oestrogenic activity. We consume more parabens through organic foods than we get from cosmetics.

How does it end? Parabens have been used safely for over 50 years. They are stable, recommended for use with sensitive skin and no link has been conclusively shown between parabens and any cancer or illness. If the thought of using them makes you uncomfortable, read the labels and buy products with alternative preservative systems. It does however remind me of an old saying,
“A rumour can run around the world before the truth gets its shoes on.”
